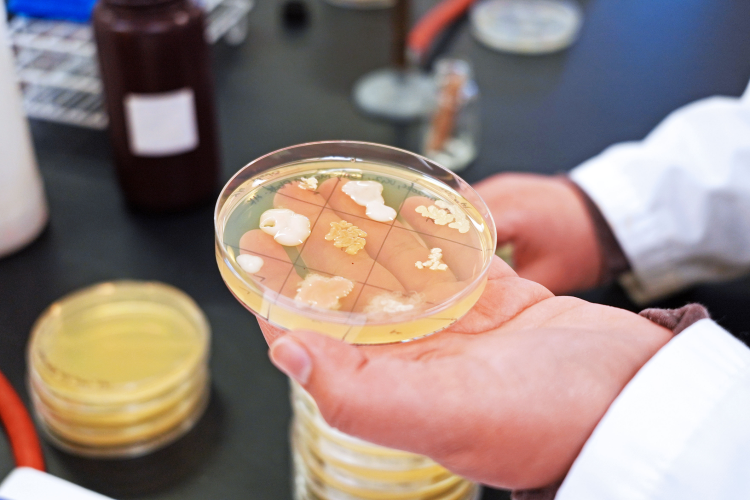

Ailish Moore is crumbling bacteria through a cheesecloth.
The old-school technique is oddly satisfying, slightly messy, but lets Moore break through the gel matrix that holds the bacteria samples she needs.
Undergraduate course trains students in research skills while they search for novel antibiotics
Recalling the course, the University of Guelph student says she felt like a kid again, playing with worms in her backyard. Unlike worms, though, there was a chance Moore's bacteria could produce an antibiotic the world has never seen before.
"This was one of my favourite courses," says Moore, who took MICR*3430, an advanced microbiology course in her third year.
It's not your typical lab where experiments are laid out step by step. Instead, undergrads must design their own projects and troubleshoot along the way.
When things go unexpectedly, as they inevitably do in science, students must consult real studies or take a step back to refine their techniques or experimental conditions.
All have their sights set on antibiotic discovery. Over weeks, they grow generations of bacteria from soil across Canada and isolate their DNA. They test the compounds that bacteria produce to see if they can work against ESKAPE pathogens - those known to "escape" the power of antibiotics and that kill millions per year, a growing number.
For many undergrads, it is their first introduction to scientific research and to the long, self-guided hours in a lab.
But lab coordinators Amanda Van Der Vinne and Catrien Bouwman hope to foster that independence, designing the series of courses that spark curiosity and build skills students can take with them forever.
"Students are so hungry for that research experience," says Van Der Vinne. "To give them that early, I think, is really meaningful for the rest of their careers."
U of G students analyze soil samples across Canada
Partnering with Tiny Earth, an international network that "studentsources" antibiotic discovery, the College of Biological Science lab tackles a major issue:

Tiny Earth "studentsources" antibiotic discovery, a process that can take years
Pathogens are becoming increasingly resistant to antibiotics, and the world desperately needs new ones.
But finding them is a difficult process. Samples must be gathered across the world, and bacteria must be isolated, grown and analyzed through countless experiments. It can take years of work. Even so, finding new antibiotics is not guaranteed; finding good ones even less so.
"It's a numbers game," Van Der Vinne says. "The more you screen, the more you're going to find."
Luckily, U of G students have the time, and they are brimming with curiosity and ideas. Lab coordinators set them loose for any kind of antibiotic project they can dream up.
Take Atti Botschner, now a first-year master's student in molecular and cellular biology, who tinkers with evolution itself. His group feeds an antibiotic to one of those ESKAPE pathogens, slowly upping the antibiotic dose and watching the pathogen evolve over generations.
"We were trying to, basically, simulate how pathogens become resistant over time," Botschner says. "And we were successful. The evolved strain was actually more resistant than the wild type, which was really cool to see."
Tiny Earth's research program is provided to more than 10,000 students a year in 27 countries. But at U of G, the experience is uniquely connected, expanded.
Soil samples are scooped up from all over Canada, from mountaintops to hop farms, to the permafrost in the Northwest Territories. From coast to coast, Vancouver Island to Newfoundland, soil collected by U of G faculty and community members is brought back to the lab just in time for the new semester. Occasionally, alumni who have loved the course return just to bring soil they collected from their backyards or from their vacations.
The experience is also planted deep in the curriculum. Science students learn about antimicrobial resistance in year one and get to work with soil samples in year two.
In year three, promising soil bacteria are pushed toward advanced research questions. Students work with whole-genome data to connect genotype and phenotype, what the genes suggest vs. what they see in the lab.
A well-known method developed by Dr. Georgina Cox, just across the hall, is used to see whether their antibiotics are known or potentially novel. Cox studies pathogenic bacteria in the Department of Molecular and Cellular Biology; she developed the method known as an antibiotic dereplication screen during her post-doc.
When all the work is done, students enter their results into Tiny Earth's global database as part of their final assessments, as coordinators encourage them to share their research with the world.
"A lot of students learn science just by learning facts," Botschner says. "But to actually learn science through doing science was really valuable."

U of G students are given the independence to pursue their own Tiny Earth projects, sharing results in global database
'Where science education is going'
Research projects like these, at the undergraduate level, are often confined to a fourth-year research project under the direct supervision of a faculty member, or work placements, both of which can be difficult to get into.
But over two undergraduate courses, Tiny Earth at U of G is known as a Course-based Undergraduate Research Experience, a CURE, that ensures everyone gets access and hidden barriers are removed, Van Der Vinne says.

While undergraduate research projects can be difficult to get into, Tiny Earth ensures barriers are removed
"Every student can see their own potential as a researcher," she says.
"It's not just a slice of society; we can all be scientists," Bouwman adds. "And these types of labs where students get to do their own, actual research, are really where science education is going."
As they hope to expand the program to include more students, more small group projects, and possibly help publish student work one day, both lab coordinators are continually innovating and want to draw more curious faculty in.
This year, they have spotted novel antibiotics in their labs. Six isolates are to be studied further, and one isolate is a potential new bacterial species that has never been characterized before.
But for both coordinators, the actual findings are almost secondary to the experience that they can give.
"I've had one student in my course say, I feel like I've regained the curiosity I had as a child,'" says Bouwman. "And that, to me, is the best thing you could ever hear."









